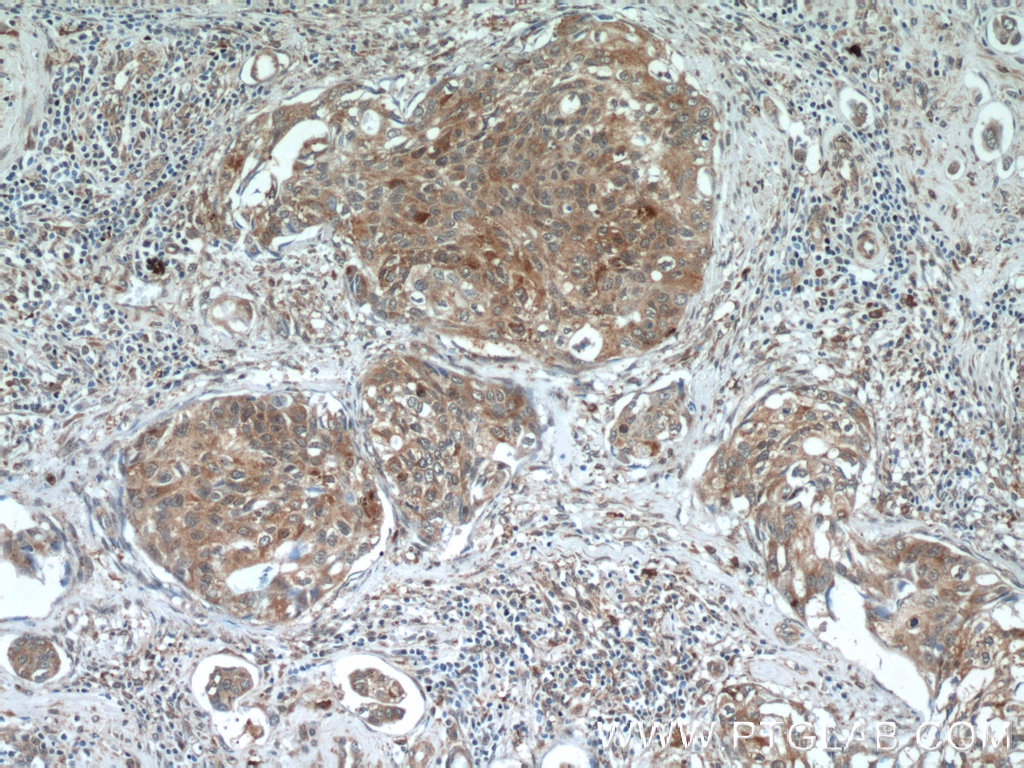

验证数据展示
经过测试的应用
| Positive WB detected in | HeLa cells, Jurkat cells |
| Positive IHC detected in | human testis tissue, human cervical cancer tissue, human colon tissue, human liver tissue Note: suggested antigen retrieval with TE buffer pH 9.0; (*) Alternatively, antigen retrieval may be performed with citrate buffer pH 6.0 |
| Positive IF/ICC detected in | HeLa cells |
推荐稀释比
| 应用 | 推荐稀释比 |
|---|---|
| Western Blot (WB) | WB : 1:1000-1:6000 |
| Immunohistochemistry (IHC) | IHC : 1:50-1:500 |
| Immunofluorescence (IF)/ICC | IF/ICC : 1:50-1:500 |
| It is recommended that this reagent should be titrated in each testing system to obtain optimal results. | |
| Sample-dependent, Check data in validation data gallery. | |
产品信息
15070-1-AP targets PCBP2 in WB, IHC, IF/ICC, IP, CoIP, RIP, ELISA applications and shows reactivity with human samples.
| 经测试应用 | WB, IHC, IF/ICC, ELISA Application Description |
| 文献引用应用 | WB, IHC, IF, IP, CoIP, RIP |
| 经测试反应性 | human |
| 文献引用反应性 | human, mouse, rat |
| 免疫原 |
CatNo: Ag7102 Product name: Recombinant human PCBP2 protein Source: e coli.-derived, PGEX-4T Tag: GST Domain: 1-362 aa of BC001155 Sequence: MDTGVIEGGLNVTLTIRLLMHGKEVGSIIGKKGESVKKMREESGARINISEGNCPERIITLAGPTNAIFKAFAMIIDKLEEDISSSMTNSTAASRPPVTLRLVVPASQCGSLIGKGGCKIKEIRESTGAQVQVAGDMLPNSTERAITIAGIPQSIIECVKQICVVMLESPPKGVTIPYRPKPSSSPVIFAGGQDRYSTGSDSASFPHTTPSMCLNPDLEGPPLEAYTIQGQYAIPQPDLTKLHQLAMQQSHFPMTHGNTGFSGIESSSPEVKGYWAGLDASAQTTSHELTIPNDLIGCIIGRQGAKINEIRQMSGAQIKIANPVEGSTDRQVTITGSAASISLAQYLINVRLSSETGGMGSS 种属同源性预测 |
| 宿主/亚型 | Rabbit / IgG |
| 抗体类别 | Polyclonal |
| 产品类型 | Antibody |
| 全称 | poly(rC) binding protein 2 |
| 别名 | hnRNP E2, Poly(rC)-binding protein 2, poly(rC) binding protein 2, HNRPE2, Alpha-CP2 |
| 计算分子量 | 39 kDa |
| 观测分子量 | 43 kDa |
| GenBank蛋白编号 | BC001155 |
| 基因名称 | PCBP2 |
| Gene ID (NCBI) | 5094 |
| RRID | AB_2236759 |
| 偶联类型 | Unconjugated |
| 形式 | Liquid |
| 纯化方式 | Antigen affinity purification |
| UNIPROT ID | Q15366 |
| 储存缓冲液 | PBS with 0.02% sodium azide and 50% glycerol, pH 7.3. |
| 储存条件 | Store at -20°C. Stable for one year after shipment. Aliquoting is unnecessary for -20oC storage. |
背景介绍
Poly(rC)-binding protein 2 (PCBP2) is a single-stranded nucleic acid binding protein that binds preferentially to oligo dC, It is also named Heterogeneous nuclear ribonucleoprotein E2, binds also poly(rU). It negatively regulates cellular antiviral responses mediated by MAVS signaling. It acts as an adapter between MAVS and the E3 ubiquitin ligase ITCH, therefore triggering MAVS ubiquitinationa and degradation.(19881509) This antibody can recognize PCBP2 and PCBP1.
实验方案
| Product Specific Protocols | |
|---|---|
| IF protocol for PCBP2 antibody 15070-1-AP | Download protocol |
| IHC protocol for PCBP2 antibody 15070-1-AP | Download protocol |
| WB protocol for PCBP2 antibody 15070-1-AP | Download protocol |
| Standard Protocols | |
|---|---|
| Click here to view our Standard Protocols |
发表文章
| Species | Application | Title |
|---|---|---|
Adv Sci (Weinh) Primate-Specific DAZ Regulates Translation of Cell Proliferation-Related mRNAs and is Essential for Maintenance of Spermatogonia | ||
Nat Commun PCBP2 maintains antiviral signaling homeostasis by regulating cGAS enzymatic activity via antagonizing its condensation.
| ||
Virol Sin Ectopic Expression of TRIM25 Restores RIG-I Expression and IFN Production Reduced by Multiple Enteroviruses 3Cpro. | ||
APL Bioeng PCBP2 promotes immune evasion via cGAS-STING pathway in biochemical recurrence of prostate cancer | ||
Mol Cancer Res PCBP2 Posttranscriptional Modifications Induce Breast Cancer Progression via Upregulation of UFD1 and NT5E.
| ||
Vet Microbiol Cellular poly(C) binding protein 2 interacts with porcine epidemic diarrhea virus papain-like protease 1 and supports viral replication.
|